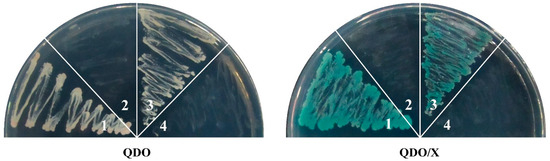
Ijms 25 08519 g0s6

In the original publication [1], there was a mistake in Figure 8. A yeast two-hybrid assay of SlMBP21 and SlMADS1 with other sepal development-related proteins was conducted. In the original figure, the “positive control” and “negative control” were wrong. The four images of the “positive control” and “negative control” were the same as the four images for “pGBKT7-SlMBP21 & pGADT7-SlMBP21” and “pGBKT7-SlMBP21 & pGADT7-SlMADS1” due to the negligence of insufficient careful inspection. In addition, the authors performed the yeast two-hybrid assay again to verify the “positive control”, “negative control”, and the interactions of “pGBKT7-SlMBP21 & pGADT7-SlMBP21" and “pGBKT7-SlMBP21 & pGADT7-SlMADS1” (please see Figure S6). The corrected version of Figure 8 appears below. The authors state that the scientific conclusions are unaffected. This correction was approved by the Academic Editor. The original publication and the supplementary material have also been updated.

Figure 8.
Yeast two-hybrid assay of SlMBP21 and SlMADS1 with other sepal development-related proteins. SlMBP21 could interact with SlMBP21, SlAP2a, TAGL1 and RIN but not with SlMADS1; SlMADS1 could interact with SlAP2a and RIN, but not with TAGL1, individually. QDO, SD medium lacking Trp, Leu, His, and adenine. QDO/X, SD medium lacking Trp, Leu, His, and adenine with X-α-Gal.
Reference
- Zhang, J.; Hu, Z.; Xie, Q.; Dong, T.; Li, J.; Chen, G. Two SEPALLATA MADS-Box Genes, SlMBP21 and SlMADS1, Have Cooperative Functions Required for Sepal Development in Tomato. Int. J. Mol. Sci. 2024, 25, 2489. [Google Scholar] [CrossRef] [PubMed]
Disclaimer/Publisher’s Note: The statements, opinions and data contained in all publications are solely those of the individual author(s) and contributor(s) and not of MDPI and/or the editor(s). MDPI and/or the editor(s) disclaim responsibility for any injury to people or property resulting from any ideas, methods, instructions or products referred to in the content. |
© 2024 by the authors. Licensee MDPI, Basel, Switzerland. This article is an open access article distributed under the terms and conditions of the Creative Commons Attribution (CC BY) license (https://creativecommons.org/licenses/by/4.0/).